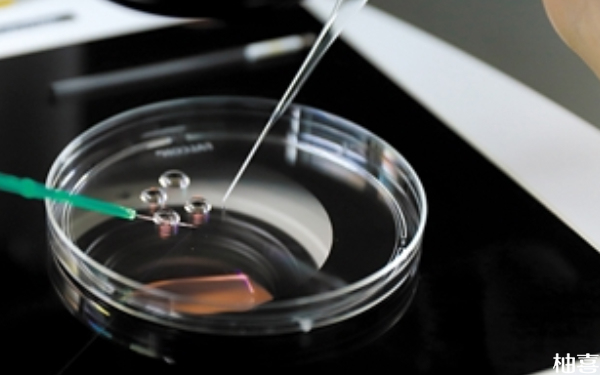

问答
频道概要
试管婴儿问答频道,汇集试管婴儿知识碎片解决不孕不育难题,发起你的备孕、怀孕问题,百万姐妹在线解答,总有一个人知道你问题的答案。
展开全部

2025年威海妇幼二代试管婴儿手术成功率高吗?
威海市妇幼保健院的生殖专家在2025年能做第二代试管婴儿,其手术成功率也比较高。威海市妇幼保健院的生殖中心配备了先进的医疗设备和专业的医疗团队,拥有丰富的临床经验,其试管婴儿成功率处于较为中等偏高水平。另外,威海市妇幼保健院的生殖中心医生还能提供个性化的治疗方案,并与患者充分沟通,确保手术过程的安全和效果。
阅读全文>
3 天前
1 个回答 · 4次浏览

2025威海妇幼二代试管转三代手术要多少钱?
截止到2025年,威海市妇幼保健院暂不能做试管二代转三代手术,有需求的患者可以到其他医院就诊,大概要花8-10万元不等。一般来说,从第二代试管转为第三代试管需要重新走流程,包括检查、降调、促排卵、取卵手术、胚胎培养、胚胎移植、基因检测等,期间产生的费用比较高。其中,促排卵、取卵费用的占比最大,整体大约在1-2万元不等。
阅读全文>
3 天前
2 个回答 · 3次浏览

青岛市立医院打短效降调针多少钱?
在青岛市立医院做试管期间需要降调,如果患者要注射短效药物的话,那么可能要花200-300元不等。目前来说,降调针分为长效和短效两种,其中长效降调针的价格相对较高,一针可能在1500元-3000元,而短效降调针的价格则相对较低,一针可能在50-100元不等。另外,影响降调的因素也比较多,包括月经周期、年龄、卵巢等,其费用没有固定标准。
阅读全文>
3 天前
2 个回答 · 2次浏览

青岛市立医院生殖科显微取精是当时出结果吗?
在青岛市立医院生殖科做显微取精手术后,其结果并不是当时出来。一般来说,患者在手术室进行显微取精后,生殖科医生还要把精子送到实验室分析,期间需要花费4-6天不等。另外,每个患者的情况不同,例如精子密度、精子活力、染色体等。如果精子质量有异常情况的话,那么还要重新做显微取精手术,此时又要等待一段时间才能得知结果。
阅读全文>
3 天前
1 个回答 · 2次浏览

青岛市立医院显微取精手术多少钱?
青岛市立医院能做显微取精手术,但是价格不低,大概要花6000元左右。然而,影响显微取精的因素比较多,包括精子密度、活动力和形态异常等,其费用没有固定标准。另外,需注意,显微取精手术对人体的影响比较大,可能会存在感染、出血、疼痛等症状,所以还要住院治疗一段时间,期间会产生一定的费用,大约在1000-2000元不等。
阅读全文>
3 天前
1 个回答 · 2次浏览
山东青岛市立医院试管第一次移植鲜胚成功率多少?
对于在山东青岛市立医院做试管的患者来说,第一次移植鲜胚的成功率不低,大约在55%左右。青岛市立医院拥有先进的设备和专业的医疗团队,为试管婴儿手术提供硬件和技术支持。其生殖中心在试管婴儿技术方面积累了丰富的经验,鲜胚移植成功率稳定在较高水平。另外,医院还提供多种助孕方案和个性化的治疗方案,满足不同需求。因此,患者可以放心就诊。
阅读全文>
3 天前
1 个回答 · 2次浏览

青岛市立医院试管第一次促排多少钱?
青岛市立医院能做试管婴儿,如果患者是第一次促排卵的话,那么可能要花5000元左右。一般来说,患者使用的促排卵药物会影响到整体费用,例如尿促性素药物的价格在200-500元不等,而卵泡刺激素药物则需要花1000-2000元不等。另外,每个患者使用的促排卵方案也会影响费用,例如超长方案、拮抗剂方案、短方案等。因此,建议患者做好资金准备即可。
阅读全文>
3 天前
2 个回答 · 5次浏览

2025青岛市立医院高龄三代试管成功率高吗?
青岛市立医院在2025年暂不支持三代试管技术,但是可做一、二代试管,因此高龄患者可以到该院移植胚胎,其着床成功率是比较高的。青岛市立医院会根据患者情况制定个性化治疗方案,以提高成功率。同时,医院也注重术前的身体调理,这有助于提升妊娠成功率,并节省一定的治疗费用。然而,需注意的是,试管婴儿会受到多种因素影响,包括年龄、子宫环境、胚胎质量等,所以也会存在失败的情况。
阅读全文>
3 天前
1 个回答 · 3次浏览

打了排卵针第三天卵泡是12*10正常吗?
女性患者做试管打了排卵针第三天卵泡大小为12*10很正常,因此各位患者不用担心,只需要保持规律的生活作息,注意防寒保暖,避免感冒,正常饮食,注意饮食多样化,并保障营养丰富即可。而在此期间不要熬夜,保证睡眠充足。另外还需要避免剧烈活动,避免久坐久卧,可进行适当活动,如散步等。
阅读全文>
3 天前
2 个回答 · 7次浏览

试管长方案用果纳芬好还是普丽康效果好?
试管长方案用果纳芬和普丽康的效果其实都相对比较不错,毕竟两种药物都具有促排作用,因个人对药物的敏感度不同,故难以比较二者的促排效果,但二者的不良反应及禁忌证有差异,因此可以根据自身的需求遵医嘱选择促排药物。只是要注意,在促排时,如果在使用一种药物后未达到促排效果,可更换为另一种。
阅读全文>
3 天前
2 个回答 · 6次浏览

三代试管移植什么胚胎是医生决定还是自己决定?
三代试管移植什么胚胎由医务工作人员和夫妻二人共同确定,其中医生一般是起到建议的作用,而最终决定的一般是不孕不育症夫妇自己。只是要注意,主要还是看患者的身体情况和获取的胚胎数量,如果身体状态良好,且数量比好多的话,移植新鲜囊胚是很不错的选择,反之身体状态不好,胚胎数量少的话,则选择三天冻胚移植会更好。
阅读全文>
3 天前
2 个回答 · 6次浏览

试管长方案是不是取卵多?
根据相关了解,不孕不育症夫妇做试管婴儿采用长方案促排取卵的数量是相对比较多的,但具体情况是因人而异的,毕竟每对夫妻的卵巢储备功能不一样,导致取卵数量存在一定差异,如果患者想要提升取卵数量,建议增加蛋白质摄入量,毕竟蛋白质是构成细胞和组织的基本元素,它对于生殖系统健康至关重要。
阅读全文>
3 天前
2 个回答 · 4次浏览

d3胚胎5细胞可以直接冷冻吗?
根据相关了解,夫妻二人做试管婴儿获取的d3胚胎5细胞一般是不能直接冷冻保存的,需要先对其进行等级质量检测,主要是根据胚胎发育情况、生长速度、胚胎卵裂球形态、胚胎细胞碎片综合起来进行等级划分。一般只有达到相关要求才能进行冷冻,否则就只能进行鲜胚移植,或者是销毁。
阅读全文>
3 天前
1 个回答 · 3次浏览

上海两个人基因检测的费用大概多少钱?
根据相关了解,上海两个人基因检测的费用大概在10000元左右,但要注意的是,具体价格多少,建议各位夫妻以自身实际情况为准,毕竟不同级别的医疗机构,定价情况是不一样的,其中三甲医院的价格可能会相对比较昂贵,而二级医疗机构的检测费用可能会比较便宜,另外,如果患者想要选择私立医院的话,开销会更为昂贵一些。
阅读全文>
3 天前
1 个回答 · 3次浏览

试管移植后屁股痒可以喷消毒液吗?
女性患者做试管移植后屁股痒一般是不可以喷消毒液的,需要保持均衡的饮食,增加水果和蔬菜的摄入,有助于改善皮肤状况。同时,避免摄入过多的刺激性食物和饮料。另外,也可以注意清洁和保湿,这样也能在一定程度上缓解屁股痒的情况,但如果还是没有缓解,则需要前往医院进行身体检查,并予以相应的治疗。
阅读全文>
3 天前
2 个回答 · 3次浏览

试管移植两个一级胚胎成功几率大吗?
试管移植两个一级胚胎成功几率是相对比较大的,因为该级别胚胎发育速度正常,卵裂球大小均匀,形状规则,透明带完整,胞质均匀、清晰,无颗粒现象,质量是非常高的,但具体是否能怀孕成功还需要考虑到凝血功能,如果该检查结果异常,容易引起局部血栓,导致子宫内膜供血不足,从而使得胚胎无法着床,即使是怀孕了,也会引起胎盘营养不够而出现流产。
阅读全文>
3 天前
2 个回答 · 3次浏览

月经十几天才干净做二代试管能移植囊胚吗?成功率高吗?
月经十几天才干净做二代试管一般是能移植囊胚的,在经过身体调理后,移植成功率是相对比较高的,但具体是否能怀孕成功,还需要考虑到自身实际情况,毕竟基因突变、长期生活习惯的不规律,如作息混乱、吸烟及酗酒等不良行为,会对女性患者的身体状态造成影响,从而引起降低试管成功率的情况。
阅读全文>
3 天前
1 个回答 · 3次浏览

做b超监测发现卵泡内见光带光点是什么意思?
女性患者做b超监测发现卵泡内见光带光点意味着快排卵了,但要注意,单纯凭借这个B超结果并不能完全确认病人是否真的排卵了。因此在进行相关计划时还需结合其他多方面的指标来进行判断。而在此期间,为保证卵泡的顺利排卵,要特别的注意个人卫生,饮食也要精心,可以尽量多吃一些新鲜水果和蔬菜,只是要避免油炸食品和甜食。
阅读全文>
3 天前
1 个回答 · 4次浏览

三代试管移植自然周期中途改人工周期需要转化内膜吗?
根据相关了解,三代试管移植自然周期中途改人工周期可能需要转化内膜,但具体是否需要进行转化,需要以医务工作人员的诊断结果和制定的移植方案,如果患者存在内膜过薄的话,则需要进行转化,反之不存在的话,就不用转化,只需要进行身体调理,等达到最佳移植标准后即可进行种植生殖细胞。
阅读全文>
3 天前
1 个回答 · 2次浏览

中午12点打完破卵针的当天晚上同房有影响吗?会怀孕吗?
根据相关了解,中午12点打完破卵针的当天晚上同房一般是没有太大影响的,如果两人生殖功能正常的话,怀孕的几率还是相对比较大的,但最好的同房时间还是打完破卵针的24或36小时左右,因为该阶段卵泡排出的几率会更大一些,只是具体是否能怀孕成功,还需要考虑到夫妻二人的精卵质量。
阅读全文>
3 天前
1 个回答 · 5次浏览

二代试管降调一直上火正常吗?
二代试管降调一直上火可能是正常的,毕竟不孕不育症女性患者在用降调针后可能会出现激素水平变化的情况,从而引起上火的现象,如果病人想要进行缓解的话,就需要改善饮食,尽量以清淡饮食、少食多餐为主,避免吃辛辣刺激性的食物。与此同时,还需要调整情绪,保持心情舒畅,避免情绪过度波动。
阅读全文>
3 天前
2 个回答 · 4次浏览

南京公立医院只有三维彩超吗?
根据相关了解,南京公立医院并不是只有三维彩超,也可以实施其他彩超项目,但要注意的是,在产检中,公立医院一般只给患者检查三维,毕竟该项目是在二维彩超的基础上,针对二维图像进行了三维重建,可以更直观地展现出三维空间结构,可以更清晰地显示人体器官形态、大小、空间关系及活动状况。
阅读全文>
3 天前
1 个回答 · 3次浏览

2024年美思满停产了吗?最新消息是什么?
截止到2024年,美思满暂时停产了。目前来说,由于原料供应不足以及日本严控人胎素出口,所以美思满面临生产困境,已经停产。另外,建议有需求的女性关注相关新闻报道或官方声明,以获取最准确的信息。同时,对于市场上出现的美思满产品,女性应保持警惕,确保通过正规渠道购买,避免购买到假冒伪劣产品。
阅读全文>
3 天前
2 个回答 · 13次浏览

Gn监测括号里的数是啥?
目前并不是很清楚Gn监测括号里的数是啥,但要注意的是,Gn监测通常是在使用GnRH激动剂或拮抗剂的过程中,监测体内激素水平的变化,以评估药物的效果以及调整治疗方案。而在此期间,需要女性患者进行身体调理,每日三餐尽量均衡搭配蛋白质、碳水化合物、脂肪和纤维质等各种营养元素。
阅读全文>
3 天前
1 个回答 · 4次浏览

原装进口的美思满怎么查真伪比较好?
对于女性来说,查原装进口的美思满产品真伪,可以观察包装与标签,例如日本原装的美思满包装简陋但手感好,文字印刷清晰。注意查看氨瓶瓶颈上是否有白点,伪造品可能会因高温杀菌氧化出现各种颜色。另外,也可以在灯光或阳光下查看封口处标签周围是否有水印痕迹。此外,还可以核对生产批号与日期,其中日本正品的生产批号日期等信息是贴上去的,而韩国正品则是直接印刷的。
阅读全文>
3 天前
1 个回答 · 7次浏览
排名
主题
关注量
- 1
99.56万
- 2
95.14万
- 3
92.33万
- 4
87.64万
- 5
86.19万
- 6
82.11万
- 7
78.52万
- 8
72.15万
- 9
69.63万
- 10
64.98万




































































